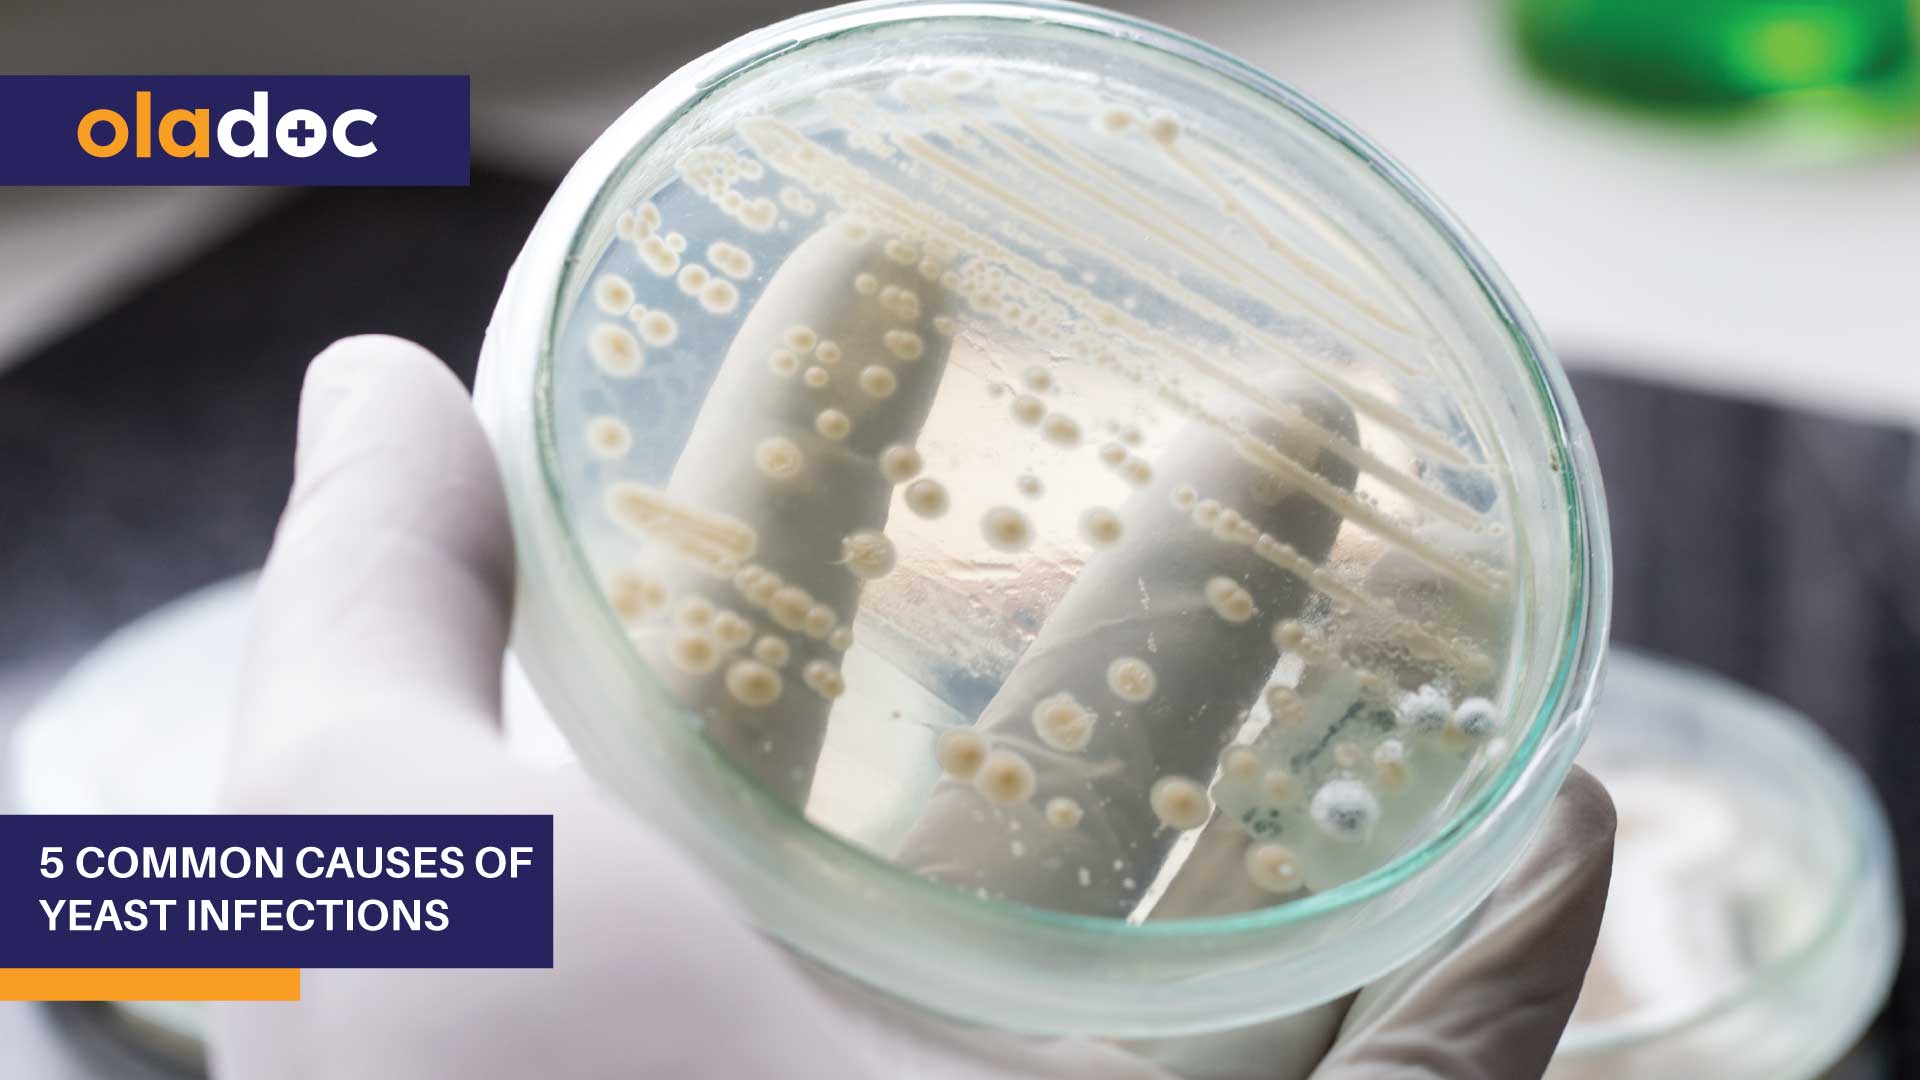

Dr. Nasir Hussain is an expert General Physician with 18 years of experience currently practicing at National Medical Centre (Karachi), Karachi. You can call our helpline 02138140600 for more information.
Experience
Dr. Nasir Hussain has over 18 years of experience in his field.
Qualifications
Dr. Nasir Hussain has the following qualifications:
- MBBS
- MCPS
- MRCP
Appointment Details
In order to book an appointment with Dr. Nasir Hussain you can call 02138140600 or click the Book Appointment button.
Fees
Dr. Nasir Hussain charges a fee of Rs. 1,500 for appointments.
Practice Locations
Dr. Nasir Hussain is currently practicing at the following locations:
Availability
- Days: M, Tu, W, Th, F
- Time: 10:00 AM - 03:00 PM
Services Offered
Following are some of the services offered by Dr. Nasir Hussain:
- Allergy & Headache Treatment
- Diabetes & Hypertension Management
- Digestive and Metabolic Problems
- Drugs and Customized Plans
- Hormonal and Medocrinal Disorder


.jpg?t=1641812980)